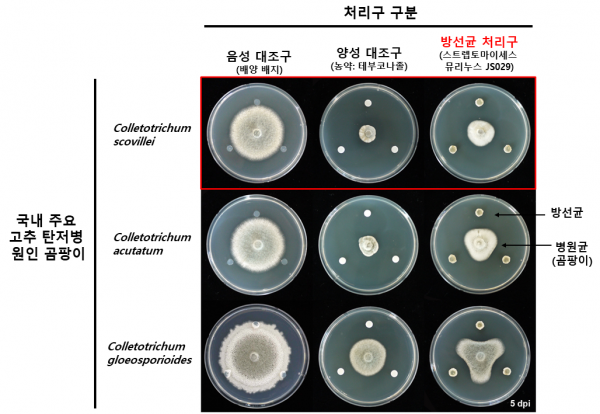

[충청25시] 환경부 소속 국립생물자원관은 우리나라 토양에서 발견한 미생물 방선균을 고추 탄저병 방제 현장에 적용한 결과, 기존 화학농약 대비 98%의 방제 효과를 최근 확인했다고 밝혔다.
국립생물자원관은 지난해 순천대 박숙영 교수 연구진과 공동으로 탄저병의 원인이 되는 곰팡이를 사멸시키는 자생 방선균의 특허를 출원하고 올해 7월에서 9월까지 전남 순천시의 야외 농지와 실내 시설에서 고추 탄저병 방제 현장 적용 연구를 수행했다.
연구진이 방선균 배양액을 500배로 희석해 하루 1회씩 3일간 고추에 분무한 결과 화학 농약인 테부코나졸 대비 98%의 예방 효과를 확인했으며 탄저병이 발병한 고추에 1회 분무 처리만으로 95%의 확산 억제 효과가 나타났다.
연구진은 이번 연구에 사용된 방선균 방제 기술이 재배 방식에 따른 차이 없이 야외와 실내에서 화학농약과 비슷한 방제 효과를 보여 다량으로 사용되는 고추 탄저병 방제용 화학농약 사용량을 감소시킬 수 있을 것으로 기대했다.
아울러 이 기술을 활용하려는 기업에 관련 기술을 이전할 계획이다.
한편 국립생물자원관은 고추 탄저병 방제 현장에 쓰인 방선균을 지난해 11월 배추 균핵병 방제 현장에도 적용해 화학농약 대비 약 80% 수준의 방제 효과를 확인했다.
그해 12월에는 ‘딸기 잿빛곰팡이병’과 ‘토마토 시들음병’에 대한 억제 효과도 확인하고 특허를 출원한 바 있다.
서민환 국립생물자원관장은 “자생 미생물자원을 이용한 친환경 생물 소재 개발을 통해 우리나라의 생물산업을 지원할 것”이라고 밝혔다.
저작권자 © 충청25시 무단전재 및 재배포 금지
